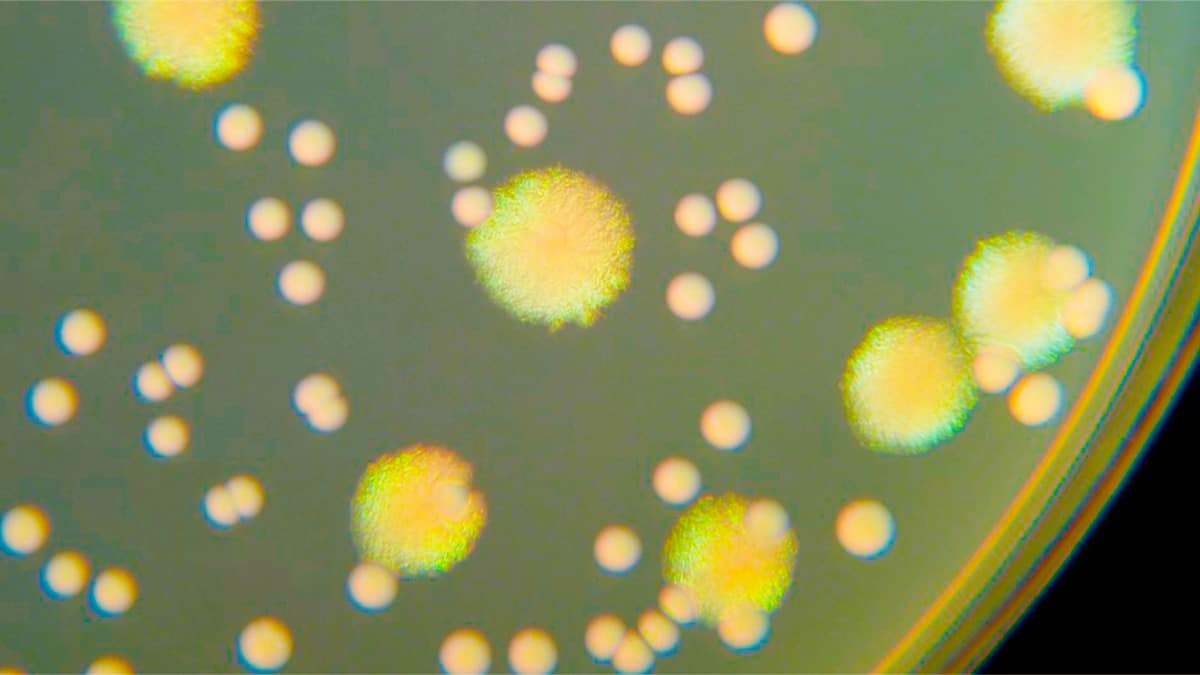

Бактерия энтерококк
Асептические продукты
Альбеа моменты затяжки
Валик полиакрил 180мм
Судьба неуловимых
Я знать хочу что чувствуешь ты
Кеннели сайкс
Да что куда
Непутевая счастливый 81
Шигандан вуконг
Фара call of duty
Орел лужки поезда
Как почистить ковры народными средствами
Вместо того чтобы помочь
Бактерия энтерококк 113 фотографий